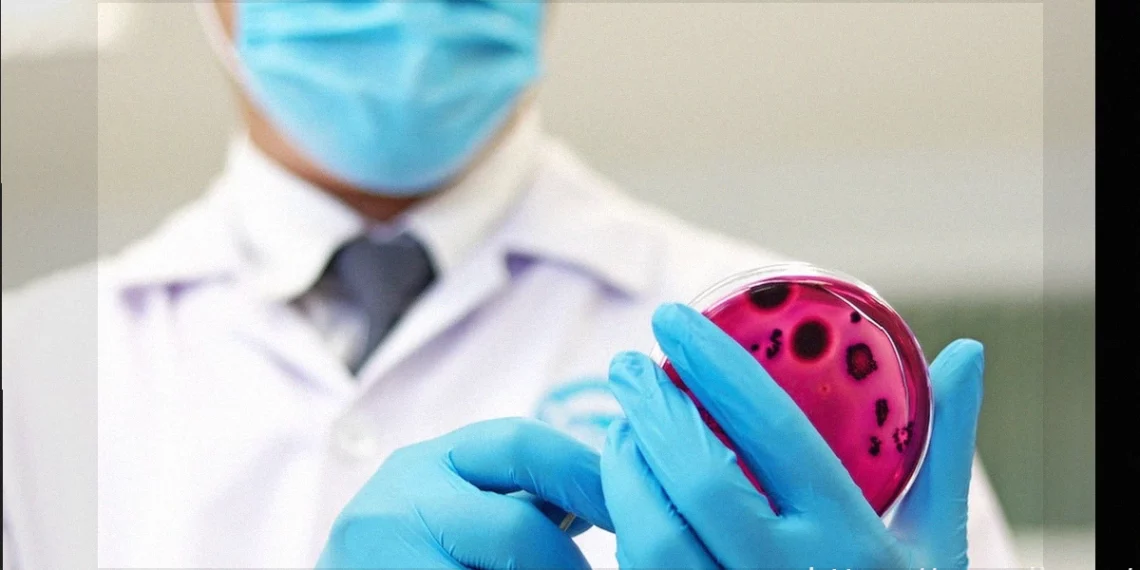
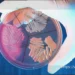

Кишечная палочка (Escherichia coli, E. coli) — это грамотрицательная бактерия, которая может вызывать различные инфекции, такие как инфекции мочевыводящих путей или гастроэнтерит. Эти состояния проявляются такими симптомами, как водянистая или кровавая диарея, а также боль или жжение при мочеиспускании.
Эта бактерия естественным образом обитает в кишечнике человека, не вызывая при этом никаких заболеваний. Однако она может легко передаваться через употребление зараженной пищи или воды, а также при дисбалансе микрофлоры в области половых органов.
Лечение инфекции, вызванной E. coli, проводится терапевтом, инфекционистом, педиатром, гастроэнтерологом или урологом. В зависимости от случая, врач может назначить покой, увеличить потребление жидкости или использовать антибиотики.

Симптомы инфекции, вызванной Escherichia coli
Основные симптомы инфекции, вызванной Escherichia coli, включают:
- Боль в животе;
- Постоянная диарея;
- Боль и жжение при мочеиспускании;
- Присутствие крови в стуле или моче;
- Мутная моча;
- Низкая, но стойкая температура.
Симптомы инфекции E. coli зависят от пораженной части тела и могут также включать тошноту, рвоту или общее недомогание. Кишечные симптомы обычно проявляются через 5-7 часов после контакта с бактерией.
E. coli при беременности
Во время беременности у женщин часто возникают инфекции мочевыводящих путей, которые в большинстве случаев вызываются Escherichia coli.
В этот период бактерия может попасть в уретру, где она размножается и вызывает такие симптомы, как боль, жжение и частые позывы к мочеиспусканию.
Лечение инфекции E. coli во время беременности всегда проводится антибиотиками, назначенными врачом. Также рекомендуется обильное питье для скорейшего выведения бактерий из мочевыводящих путей.
Тест на кишечную инфекцию, вызванную E. coli
Тест на симптомы является лишь ориентировочным инструментом и не служит для диагностики, а также не заменяет консультацию терапевта, инфекциониста, педиатра или гастроэнтеролога.
Как происходит передача
Бактерия E. coli может передаваться следующими способами:
- Употребление пищи или воды, зараженных бактерией;
- Контакт с фекалиями инфицированного человека;
- Плохая гигиена половых органов (например, подтирание ануса сзади вперед);
- Недостаточное мытье рук после дефекации;
- Использование мочевых катетеров или механической вентиляции легких в больничных условиях.
Передача этой бактерии особенно легка среди детей, например, в школах или детских садах.
Заболевания, вызываемые E. coli
Основные заболевания, вызываемые бактерией E. coli:
1. Гастроэнтерит
Гастроэнтерит, вызванный E. coli, — это инфекция желудочно-кишечного тракта, которая может возникнуть из-за употребления зараженной воды и пищи, вызывая высокую температуру, водянистую и кровавую диарею, тошноту или боль в животе.
2. Диарея путешественников
Бактерия E. coli также может вызывать диарею путешественников, особенно у людей, которые ездят в страны с плохими санитарными условиями или недостаточной гигиеной и хранением продуктов питания. Другие бактерии, которые могут вызывать диарею путешественников, включают Campylobacter jejuni, Shigella или Salmonella sp.
3. Инфекция мочевыводящих путей
Инфекция мочевыводящих путей, вызванная E. coli, может возникнуть из-за изменений в балансе микрофлоры половой области, плохой интимной гигиены или длительного сдерживания мочеиспускания, например. Эта инфекция чаще встречается у женщин из-за близости уретры к анусу, что способствует проникновению E. coli из кишечника в мочевыделительную систему.
4. Пневмония
Пневмония — еще одно заболевание, которое может быть вызвано бактерией E. coli, особенно в условиях стационара. Эта бактерия может попасть в легкие через аспирацию ротоглоточных выделений или через кровоток из-за желудочно-кишечных или мочевых инфекций. Пневмония, вызванная E. coli, также может возникнуть из-за искусственной вентиляции легких.
5. Бактериемия
Если инфекция, вызванная Escherichia coli, не лечится должным образом, бактерия может попасть в кровоток, вызывая бактериемию — серьезное состояние, которое обычно лечится в стационаре.
6. Перитонит
Перитонит — это инфекция брюшины, мембраны, которая окружает брюшную полость и покрывает органы брюшной полости. Он может быть вызван бактерией E. coli. Обычно этот тип инфекции чаще встречается у людей с асцитом, вызванным циррозом печени.
Как проводится лечение
Лечение инфекции, вызванной Escherichia coli, должно проводиться под наблюдением терапевта, инфекциониста, педиатра, гастроэнтеролога или уролога, в зависимости от типа E. coli, симптомов и общего состояния здоровья.
При наличии симптомов, особенно в случае инфекции мочевыводящих путей, врач может рекомендовать использование антибиотиков, таких как цефалоспорины, левофлоксацин и ампициллин.
В случае кишечной инфекции обычно не рекомендуется применение антибиотиков, так как это состояние имеет тенденцию разрешаться самостоятельно в течение нескольких дней; рекомендуется только покой и обильное питье.
Как предотвратить инфекцию
Профилактика заражения E. coli включает в себя:
- Мытье рук после посещения туалета;
- Мытье рук всегда перед едой;
- Мытье рук до и после приготовления пищи;
- Тщательное мытье сырых продуктов, таких как салат и помидоры;
- Не глотать воду из бассейна, реки или моря.
Кроме того, важно дезинфицировать сырые продукты, замачивая их полностью в растворе из 1 столовой ложки хлорного отбеливателя на каждый литр питьевой воды на пятнадцать минут перед употреблением.